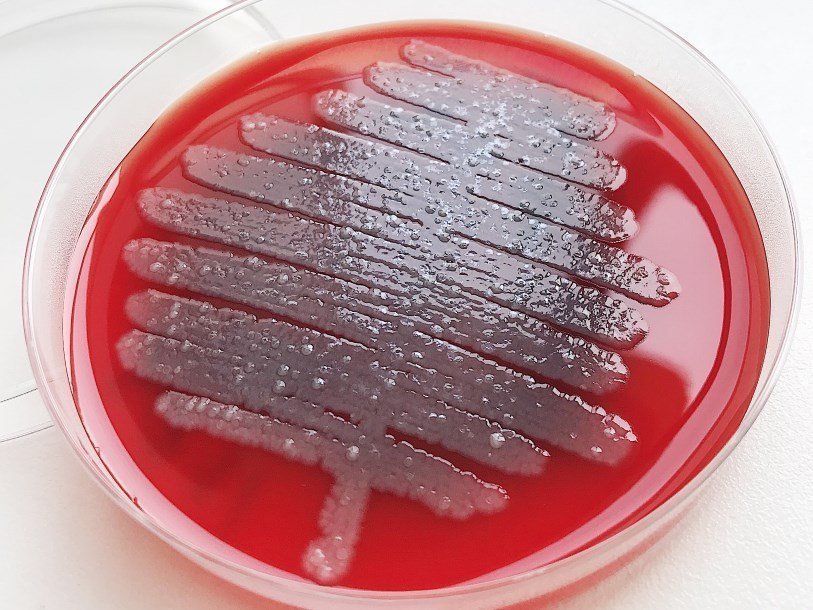

Екатерина Беленко: Промикробы: Знакомьтесь, синегнойная палочка!
Pseudomonas aeruginosa в чашке Петри Екатерина Беленко
Pseudomonas aeruginosa в чашке Петри Екатерина Беленко Представляю, как особо нежные натуры после слова «синегнойная» нервно поморщились. После следующего предложения вы вообще к туалету побежите. Колонии синегнойной палочки (а по-умному её звать Pseudomonas aeruginosa) легко отличить от всех остальных микробов по очень характерному запаху. Но нет — не гноя, а фиалок или жасмина, кто как это ощущает. Вот такой сюрприз!
⠀
Чем опасна эта пахучая красотка? Тем, что является самым распространённым возбудителем нозокомиальных инфекций. Не бегите гуглить, сейчас расскажу, что это такое. Это заболевания микробного происхождения, поражающие больного в результате его госпитализации или посещения лечебного учреждения, — например, пневмонии, инфекции мочевыводящих путей, крови и других органов. Опасны такие инфекции тем, что трудно поддаются лечению по причине антибиотикорезистентности. Бывает, что при определении чувствительности к антибиотикам оказывается, что ни один антибиотик (из тех, что у нас есть) не в силах убить микроорганизм.
⠀
Устойчивость к антибиотикам может развиваться в результате естественного отбора или благодаря воздействию антибиотика. А потом щедрые микроорганизмы охотно своими новыми прикольными навыками делятся путём горизонтального переноса генов. И это возможно даже между представителями разных штаммов и видов. Вот и получается, что живущие в больнице микробы — и так самые сильные Рэмбо микромира, их уже били-били, а они крепчали. Дальше ещё поменялись генами, будто это футбольные карточки, и... вуаля —суперустойчивый возбудитель.
⠀
P. аeruginosa распространена повсеместно, существенное значение в циркуляции возбудителя имеет вода, в которой он может выживать до года при температуре 37 °С. Прикиньте, год на одной воде! В том числе живёт во многих растворах, применяемых в медицине (например, жидкость для хранения контактных линз). Все дружно пошли и проверили срок годности глазных капель и жидкости для линз, выключили Плюшкина и повыкидывали всю просрочку! А я пока понюхаю чашку Петри, очень уж хорошо пахнет.
Смотрите также: Екатерина Беленко Промикробы: моча, окутанная мифами Екатерина Беленко Промикробы: Загадочный дисбактериоз Екатерина Беленко Среда для микробиологов Екатерина Беленко Микробы, они везде Новое Татьяна Пигарева Испания от И до Я Сергей Сергеев Русское самовластие. Власть и ее границы: 1462–1917 гг. Катерина Михалева-Эгер 350 лет современной моды Леонид Чутко Сил нет Катя Колпинец Формула грез Сергей Плохий Забытые бастарды Восточного фронта Дэвид Чиверс, Том Чиверс Цифры врут. Как не дать статистике обмануть себя Пол Стейнхардт Невозможность второго рода Стивен Хоффман Пять сил, изменяющих все Уолтер Айзексон Взломавшая код Рустам Александер Закрытые. Жизнь гомосексуалов в СССР 3D-каркасы для восстановления костной ткани Платиновый бутерброд для спинтроники